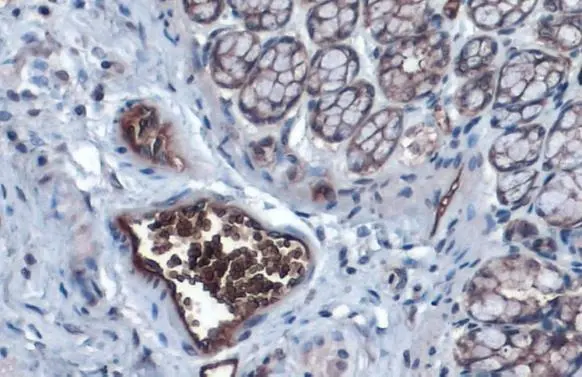
Aquaporin 1 antibody detects Aquaporin 1 protein at cell membrane and cytoplasm by immunohistochemical analysis. Sample: Paraffin-embedded rat colon. Aquaporin 1 stained by Aquaporin 1 antibody (GTX132870) diluted at 1:1000. Antigen Retrieval: Citrate buffer, pH 6.0, 15 min

Various whole cell extracts (30 μg) were separated by 12% SDS-PAGE, and the membrane was blotted with Aquaporin 1 antibody (GTX132870) diluted at 1:1000. The HRP-conjugated anti-rabbit IgG antibody (GTX213110-01) was used to detect the primary antibody.
Aquaporin 1 antibody
GTX132870
ApplicationsWestern Blot, ImmunoHistoChemistry, ImmunoHistoChemistry Paraffin
Product group Antibodies
ReactivityHuman, Mouse, Rabbit, Rat
TargetAQP1
Overview
- SupplierGeneTex
- Product NameAquaporin 1 antibody
- Delivery Days Customer9
- Application Supplier NoteWB: 1:500-1:3000. *Optimal dilutions/concentrations should be determined by the researcher.Not tested in other applications.
- ApplicationsWestern Blot, ImmunoHistoChemistry, ImmunoHistoChemistry Paraffin
- CertificationResearch Use Only
- ClonalityPolyclonal
- Concentration1.17 mg/ml
- ConjugateUnconjugated
- Gene ID358
- Target nameAQP1
- Target descriptionaquaporin 1 (Colton blood group)
- Target synonymsAQP-CHIP, CHIP28, CO, aquaporin-1, Colton blood group antigen, aquaporin 1 (channel-forming integral protein, 28kDa, CO blood group), aquaporin 1, Colton blood group antigen, aquaporin-CHIP, bloodgroup CO protein, channel-like integral membrane protein of 28 kDa, channel-like integral membrane protein, 28-kDa, urine water channel, water channel protein for red blood cells and kidney proximal tubule
- HostRabbit
- IsotypeIgG
- Protein IDP29972
- Protein NameAquaporin-1
- Scientific DescriptionThis gene encodes a small integral membrane protein with six bilayer spanning domains that functions as a water channel protein. This protein permits passive transport of water along an osmotic gradient. This gene is a possible candidate for disorders involving imbalance in ocular fluid movement. [provided by RefSeq, Aug 2016]
- ReactivityHuman, Mouse, Rabbit, Rat
- Storage Instruction-20°C or -80°C,2°C to 8°C
- UNSPSC41116161